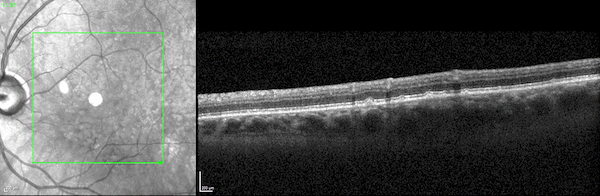

Meta Introduces New AI Tools and Nordic Banks Bet on AI
In todays Download: Meta launches new AI models, Adobe unveils 3D AI tools, and Nordic banks are investing heavily in AI to counter competition from digital rivals. Also, get the latest news on AI and innovation in the healthcare sector.
Todays Download
🤓📘 Meta Unveils New AI Models and Tools

Meta FAIR (Fundamental AI Research) has just presented an impressive array of new research models and datasets, marking a major step forward across several AI disciplines. Highlights include an updated image segmentation tool, a multimodal language model, and a groundbreaking solution to accelerate the performance of large language models (LLMs).
Spirit LM: This new open-source language model is multimodal, meaning it combines both speech and text. The model allows for generating more natural and expressive speech, applicable in everything from virtual assistants to AI-driven interaction systems. By combining different modalities, Spirit LM aims to improve the way AI systems understand and replicate human communication.
SAM 2.1: Meta’s Segment Anything Model (SAM) has been updated, now offering enhanced image and video segmentation. This tool has already gained significant popularity, with the original version being downloaded over 700,000 times in just 11 weeks. SAM 2.1 promises faster and more precise segmentation, which could revolutionize everything from image processing to video editing and autonomous vehicles.
Layer Skip: Meta also introduces a new tool called Layer Skip, which offers an end-to-end solution for doubling the speed of LLM generation without requiring specialized hardware. This is a major step forward, especially at a time when many companies are striving to optimize the efficiency of AI systems to reduce the costs of large language models.
In addition, Meta is launching several new tools, including SALSA, designed for safety testing of AI models, and Meta Lingua, which helps train linguistic AI models. Meta once again demonstrates that their open-source approach can help push AI development forward, where the line between closed and open systems appears to be blurring.
If you're enjoying Nerdic Download please forward this article to a colleague.
It helps us keep this content free.
🖼️ Adobe Showcases New AI Tools for 3D and Animation

At their annual MAX 2024 conference, Adobe showcased several experimental AI-driven tools aimed at making it easier for creative creators to work with 3D, animation, and video editing.
Project Scenic: This tool allows users to build 3D scenes, which can then be converted into 2D images with greater control and precision. This provides creators with a flexible way to move between 3D and 2D in their workflow, creating new possibilities in visual art and design.
Project Motion: For those working with animation, Adobe now offers a tool that can take simple animated graphics and transform them into more complex animations using text descriptions. This allows for the creation of detailed animations without having to manually draw each movement, saving time and resources.
Project Clean Machine: This tool is targeted at video editing and can remove unwanted objects or disturbances in videos and photos, such as camera flashes or unwanted people in the background. This technology could be revolutionary for filmmakers and photographers seeking more control over their images.
Although these tools are still in the experimental stage, they demonstrate how AI can help creative professionals save time while giving them more control over their projects.
💳 Nordic Banks Bet on AI to Compete Against Digital Rivals
Traditional Banks in the Nordics, Including Major Players Like Danske Bank, Nordea, and SEB, Are Significantly Increasing Their Investments in Artificial Intelligence to defend their market share against rapidly growing digital banks. Traditional banks are under pressure from smaller, digital competitors who leverage technology to offer faster and more user-friendly services.
Nordic banks are especially focusing on partnerships with tech companies and the development of their own AI solutions to reduce operational costs and improve customer experiences. For example, SEB in Sweden has implemented programming methods that enable teams to work more efficiently by using AI to solve complex tasks faster. Danske Bank is also using AI to combat money laundering, one of the most pressing challenges in the banking sector.
🧠 AI Reaches Expert Level in Medical Scans

Researchers at UCLA have developed a new AI model named SLIViT (Slice Integration by Vision Transformer), which has the potential to revolutionize how we diagnose diseases through medical scans. The model can analyze complex 3D imaging data, such as MRI and CT scans, with expert-level accuracy—and it does so 5,000 times faster than human specialists.
SLIViT uses advanced transfer learning technology, which allows the model to be trained on relatively small datasets while still achieving high precision. This means that even healthcare providers with limited resources can benefit from AI technology.
The model has the potential to be a game-changer in medical imaging analysis, especially at a time when the demand for faster and more accurate diagnostic tools is on the rise.
💼 Former Palantir CISO Joins OpenAI
Dane Stuckey, who previously served as Chief Information Security Officer (CISO) at Palantir, has now joined OpenAI as the new CISO. Stuckey, who has many years of experience in security roles within both commercial and government sectors, will focus on strengthening OpenAI's security measures, particularly in relation to the company's growing ambitions in AI projects related to government and defense.
🏗️ AMD Acquires Silo AI to Accelerate AI Development

AMD has just completed the acquisition of the Finnish AI startup Silo AI in a transaction valued at $665 million. Silo AI is one of the largest private AI laboratories in Europe, known for developing advanced language models, including Viking LLM, which supports multiple Nordic languages such as Danish, Finnish, and Swedish.
Silo AI's expertise in open-source AI solutions, used by major companies like Allianz and Rolls-Royce, will now strengthen AMD's AI group, led by Senior VP Vamsi Boppana. The acquisition aims to position AMD as a leading player in AI solutions based on open standards.
⚡ Quick News
H2O.ai has launched new AI models that offer efficient document analysis, competing with larger models from tech giants.
Claude app has undergone a major redesign, enhancing the user experience and now including an iPad version for broader use.
Perplexity AI is planning a new fundraising round that could double the company's value to over $8 billion, according to the Wall Street Journal.
Apple is reportedly over two years behind in AI technology compared to competitors, according to Bloomberg insider Mark Gurman.
Midjourney will launch a new tool this week that allows users to edit uploaded images using the AI model, along with new retexturing options. Initially, access will be limited to a small test group.


Reply